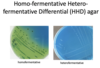

Lactic acid bacteria Flashcards
(58 cards)
What is the formula of lactic acid
What are the other names
CH3CH(OH)COOH
Hydroxypropanoic, milk acid

How lactic acid is produced in nature?
- In food fermentations, lactic acid is produced from the break-down of simple carbohydrates such as glucose, sucrose, or galactose by lactic acid bacteria (LAB).
- LAB also grow in your mouths and the acid they produce is responsible for tooth decay and cavities.
- Lactic acid (actually L-lactate) also is produced in your muscles during exertion
Why lactic acid has acidic properties
The hydrogen atoms can separate from the rest of the molecule, by ionization, and this gives lactic acid its acidic properties
CH3CH(OH)COOH ⇌ CH3CH(OH)COO− + H+
What sugars can be used for lactic acid fermentation
•Almost any C5 or C6 sugar can be used for lactic acid fermentation (pure sucrose, glucose from starch, or raw sugar)
What classes of lactic acid bacteria are there and how they are different?
•Lactic acid bacteria can be divided into two classes:
–Homofermentative bacteria can produce two moles of lactate from one mole of glucose:
C6H12O6 → 2CH3COCO2− + 4H+ + H2O
–Heterofermentative species can produce one mole of lactate from one mole of glucose, and produce carbon dioxide and acetic acid or ethanol as biproducts:
C6H12O6 → CH3COCO2− + CO2 + CH3CO2H + 3H+
How does Homo-fermentative Hetero-fermentative Differential Agar works? What are the constituetns?
- Medium constituents like casein enzymic hydrolysate, papaic digest of soybean meal and yeast extract supply all the necessary nutrients for the growth of lactic bacteria. Fructose is the fermentable carbohydrate in the medium. Bromo cresol green is the pH indicator. Heterofermentative lactic acid bacteria produce CO2, lactic acid, acetic acid, ethanol and mannitol. Homofermentative lactic acid bacteria produce only lactic acid.
- Homofermentative lactic acid bacteria produce lactic acid from fructose and is indicated by yellow colour formation.
- Heterofermentative lactic acid bacteria induce lesser acidification and thus vary in the colour formation by the indicator in the medium.
- Homofermentative bacteria cultivated on this medium form bluish-green colony on agar while heterofermentative bacteria form white colonies on agar surface
Are LAB gram positive or negative?
positive
Do LAB form spores and what shape
•These bacteria are non-sporeforming and can be both rods and cocci
Where LAB is found in human?
•They are commonly found on (healthy) mucosal surfaces of both humans and animals (mouth, intestine, vagina)
What are 5 genera of LAB that we should know
Enterococcus, Lactobacillus, Lactococcus, Leuconostoc, Streptococcus
Are bifidobacterium related to LAB
•Bifidobacterium is often considered a LAB, however it is phylogenetically unrelated, and has a unique mode of sugar fermentation
How LAB survive in the environment? What is their advantage?
- LAB are very adapted to environments that are rich in nutrients and energy sources (and have limited biosynthetic capability)
- LAB have several strategies to compete with other organisms (an important one being acid production and acid tolerance)
How LAB are used? Are they widespread?
- LAB are involved in dairy, vegetable, and cereal fermentations
- LAB are the most popular and most widely available human and animal probiotics
- They are used to decrease the occurrence of disease in fish farms
- LAB are a major part of the human microbiome (mouth, gut, vagina)
•The genera Enterococcus, Lactococcus, Streptococcus, and Vagococcus were earlier included in the ____
Streptococcus genus
Only one Streptococcus species is associated with food__, with what organism they are working in pair?
• S. thermophilus, which is used to manufacture yogurt, usually in co-culture with Lactobacillus delbruckii subsp. bulgaricus, and certain cheeses.
What genus is associated with dairy products? and one species that is commonly used in dairy technology
•Lactococcus is intimately associated with dairy products, but only one species, Lactococcus lactis is commonly used in diary technology
How Vagococcus and Enterococcus are related to food?
•Vagococcus and Enterococcus are not commonly used in food, and some species of Enterococcus are known foodborne pathogens (E. faecalis)
What are tetrad-forming LAB
What are the species that do that?
Why this class is important?
The tetrad occurs in a subgroup of the cocci where the bacterium divides in two planes to form a square of four bacteria called a tetrad.
Aerococcus, Pediococcus, and Tetragenococcus
•Tetragenococcus are extremely salt tolerant (>18% NaCl) and are important in high-salt containing food like soy-sauce
Why aerococcus is popular
•Aerococcus is not used in the food industry but is responsible for greening of cooked meat products
Why P.damnosus is popular?
•P. damnosus is a spoilage organism in the beer industry and is responsible for the buttery taste in beer
Why P.acidilactici and P.pentosaceus are popular?
•P. acidilactici and P. pentosaceus are both used as starter for sausage making and silage inoculants
Leuconostoc, Oenococcus, and Weisella- how you can categorize them? Why they are important?
- Leuconostoc, Oenococcus, and Weisella are each coccoid LAB
- Leuconostocs are important for spontaneous vegetable fermentations like sauerkraut
- Weissella species are associated with meat and can proliferate at low temperatures
What is the largest genera of LAB
Lactobacillus
What are three groups of Lactobacillus? what is the difference between them?

